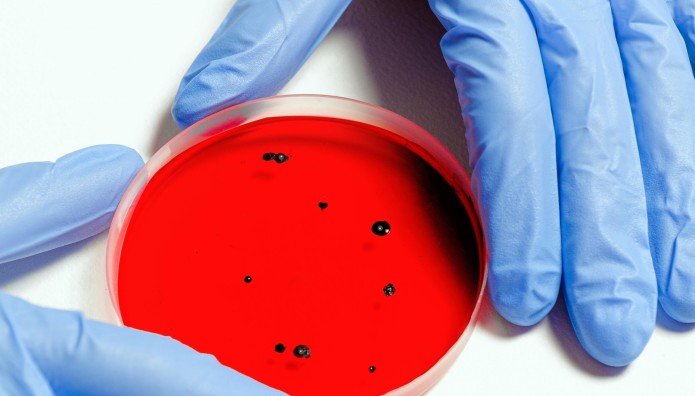
Λιστερίωση

Συναγερμός έχει σημάνει λόγω της σημαντικής αύξησης που καταγράφουν τα κρούσματα λιστερίωσης στην Ελλάδα. Συνολικά, το διάστημα 2004-2023 δηλώθηκαν 266 κρούσματα λιστερίωσης στη χώρα μας.
Τι είναι η λιστερίωση
Η λιστερίωση είναι ένα τροφιμογενές νόσημα, που προκαλείται από το αναερόβιο Gram θετικό βακτήριο Listeria monocytogenes. Η θνητότητα της λιστερίωσης είναι μεγάλη σε σύγκριση με τα άλλα τροφιμογενή νοσήματα. Εκδηλώνεται κατά κανόνα σε εγκύους, νεογέννητα, ηλικιωμένους, καθώς και σε ανοσοκατεσταλμένα άτομα. Τα συμπτώματα ποικίλλουν από ήπια συμπτώματα γριπώδους συνδρομής ή γαστρεντερίτιδας, μέχρι σοβαρά συμπτώματα από το κεντρικό νευρικό σύστημα. Το βακτήριο είναι υπεύθυνο κυρίως για την εμφάνιση μεμονωμένων κρουσμάτων, ωστόσο τα τελευταία χρόνια έχουν περιγραφεί αρκετές επιδημίες, που έχουν προκληθεί από κατανάλωση διαφόρων ειδών τροφίμων όπως μαλακά τυριά, σολωμός, κατεψυγμένα λαχανικά. Η επιτήρηση της λιστερίωσης μέσω του Συστήματος Υποχρεωτικής Δήλωσης Νοσημάτων (ΣΥΔΝ) ξεκίνησε στην Ελλάδα το 2004.
Τα κρούσματα λιστερίωσης
Συνολικά, το διάστημα 2004-2023 δηλώθηκαν 266 κρούσματα λιστερίωσης στη χώρα μας. Ο μέσος ετήσιος αριθμός των κρουσμάτων ήταν 13,3 (τυπική απόκλιση: 8,8). Κατά το χρονικό διάστημα 01/01/2023-31/12/2023 δηλώθηκαν μέσω του ΣΥΔΝ, 31 κρούσματα λιστερίωσης. Η διάμεση τιμή του αριθμού των κρουσμάτων για την περίοδο 2004-2022 ήταν 10 (IQR: Q3-Q1= 20-7=13). Από τα 31 κρούσματα, 2 διακομίστηκαν σε υγειονομικές μονάδες του εξωτερικού, λόγω του ότι ήταν αλλοδαπής εθνικότητας και δεν ήταν δυνατή η παρακολούθηση της έκβασής τους. Στο σύνολο των υπόλοιπων 29 κρουσμάτων, 11 (37,9%) κατέληξαν. Η διάμεση ηλικία των ασθενών ήταν 67 έτη (ελάχιστη: 0 έτη, μέγιστη: 92 έτη) ενώ 18 (58,1%) ήταν άνδρες. Τρία κρούσματα ήταν μόνιμοι κάτοικοι εξωτερικού και ένα εξ’ αυτών, εισαγόμενο. Σχετικά με την περιοχή κατοικίας για τα υπόλοιπα 28 κρούσματα: 9 (32,1%) άτομα ήταν κάτοικοι Περιφέρειας Αττικής, 6 (21,4%) ήταν κάτοικοι Περιφέρειας Κρήτης, 4 (14,3%) ήταν κάτοικοι Περιφέρειας Δυτικής Ελλάδας και 9 ήταν κάτοικοι διαφορετικών μεταξύ τους Περιφερειών. Δεκαοκτώ (58,1%) κρούσματα είχαν εκδηλώσεις από το Κεντρικό Νευρικό Σύστημα. Στο σύνολο των 29 κρουσμάτων, 19 (65,5%) ήταν ανοσοκατεσταλμένα άτομα, 2 (6,9%) ήταν εγκυμονούσες και 2 (6,9%) ήταν νεογνά. Σε μία (1-50%) εκ των δύο εγκύων, επήλθε αυτόματη αποβολή και σε μία (1-50%) πρόωρος τοκετός. Στο Διάγραμμα παρουσιάζεται η δηλούμενη επίπτωση της λιστερίωσης ανά έτος για την περίοδο 2004-2023.
Το φαινόμενο εξακολουθεί να παρατηρείται και το 2024, όπου έως και τις 11/04/2024 δηλώθηκαν 12 κρούσματα λιστερίωσης.
«Τραγική η κλινική εικόνα με κoκκύτη» - Ποια είναι τα συμπτώματα στα παιδιά
Οι ενέργειες του ΕΟΔΥ για τον περιορισμό της εξάπλωσης της λιστερίωσης
Ο ΕΟΔΥ στο πλαίσιο της λήψης μέτρων για την προστασία της δημόσιας υγείας έχει προβεί στις ακόλουθες ενέργειες:
Ενημέρωση των υγειονομικών μονάδων όλης της χώρας σχετικά με το φαινόμενο και τις διαδικασίες που πρέπει να ακολουθούνται ως προς τη δήλωση των κρουσμάτων στον ΕΟΔΥ και την αποστολή των κλινικών καλλιεργημάτων στο Εθνικό Κέντρο Αναφοράς Σαλμονελλών, Σιγκελλών, δονακίων χολέρας, Λιστέριας και λοιπών εντεροπαθογόνων (ΕΚΑΣΣ) για περαιτέρω τυποποίηση.
Ενημέρωση του Ενιαίου Φορέα Ελέγχου Τροφίμων (ΕΦΕΤ) και του Υπουργείου Αγροτικής Ανάπτυξης και Τροφίμων (ΥΠΑΑΤ), συμπεριλαμβανομένης της Διεύθυνσης του Κτηνιατρικού Κέντρου Αθηνών (ΚΚΑ), που αποτελεί Εθνικό Εργαστήριο Αναφοράς για τη Listeria monocytogenes σε τρόφιμα, σχετικά με α) το φαινόμενο, β) την ανταλλαγή δεδομένων για τη διαπίστωση πιθανής αύξησης ανιχνεύσεων Listeria monocytogenes σε δείγματα τροφίμων ή σε πληθυσμούς ζώων και γ) την αποστολή καλλιεργημάτων από τρόφιμα στο ΕΚΑΣΣ για εργαστηριακό έλεγχο και σύγκριση με τα κλινικά καλλιεργήματα.
Συνεργασία με το ΕΚΑΣΣ και το Κεντρικό Εργαστήριο Δημόσιας Υγείας για αποστολή γενετικού υλικού των κλινικών καλλιεργημάτων σε συνεργαζόμενο με το ECDC εργαστήριο για αλληλούχηση ολικού γονιδιώματος (Whole Genome Sequencing) με στόχο την αναγνώριση πιθανών συρροών καθώς και τη διασύνδεσή τους με διακρατικές επιδημίες.
Ανάρτηση ενημερωτικού υλικού στην ιστοσελίδα του ΕΟΔΥ σχετικά με την πρόληψη της λιστερίωσης κατά τη διάρκεια της κύησης.
Σύσταση Ομάδας Εργασίας για την ανταλλαγή δεδομένων σε περίπτωση εμφάνισης μεμονωμένων/συρροών κρουσμάτων τροφιμογενών νοσημάτων. Στην ομάδα συμμετέχουν εκπρόσωποι από τον ΕΟΔΥ, τη Διεύθυνση Δημόσιας Υγείας του Υπουργείου Υγείας, τον ΕΦΕΤ, το ΥΠΑΑΤ, Διευθύνσεις Αγροτικής Οικονομίας και Κτηνιατρικής της Περιφέρειας Αττικής, το ΚΕΔΥ, το ΕΚΑΣΣ και το Εθνικό και Καποδιστριακό Πανεπιστήμιο Αθηνών. Στο πλαίσιο των εργασιών της Ομάδας έχει τεθεί προς συζήτηση η παρατηρούμενη αύξηση με στόχο το συντονισμό ενεργειών για την αντιμετώπιση του φαινομένου.
Διαβάστε όλες τις ειδήσεις από την Ελλάδα και τον Κόσμο.